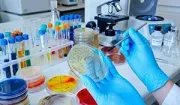
A scientist in blue gloves holds a petri dish containing bacterial colonies in a laboratory setting.

Restore and Protect Your Home with NEPA Environmental
Protecting your home from hidden threats with advanced testing, 24/7 emergency response, and safe, eco-friendly restoration—so your family can breathe easier.



Serving Wayne, Pike, Monroe & Lackawanna homes.
Your Home’s Health, Our Top Priority in NEPA
Certified experts in mold, water, and odor solutions for homes in Hawley, Lake Wallenpaupack, and nearby counties—trust your local specialists.
Safe Homes Start Here
Home Restoration Experts for Northeast Pennsylvania
Your home is your sanctuary, but in Northeast Pennsylvania, hidden threats like mold, water damage, and lingering odors can jeopardize your comfort and safety. At NEPA Environmental, we specialize in protecting homes throughout Hawley, Lake Ariel, and the greater Wayne, Pike, Monroe, and Lackawanna counties. Our approach brings the same meticulous, safety-first standards used for high-risk materials directly to residential mold and water mitigation. Whether you’re a year-round resident or manage a cherished secondary home along Lake Wallenpaupack, we deliver peace of mind with advanced testing methods, USDA-approved products, and documented results. Our local team responds quickly—especially during the spring thaw, when frozen pipes can create hidden water damage. Choose NEPA Environmentalfor honest, high-integrity restoration that puts your home and family first.
Trusted. Tested. Local.
Why Homeowners Trust NEPA Environmental
Local expertise, lab-verified results, and a commitment to your family’s health make us Northeast PA’s home restoration leader.
Lab-certified mold testing for faster, accurate results in your home.
USDA-approved, eco-friendly products—safe for children, pets, and plants.
24/7 emergency water mitigation to protect homes from sudden floods.
Direct insurance coordination—reducing stress for homeowners in crisis.
Locally owned, with a crew committed to meticulous, honest service.

Mold Remediation
Remove mold at the source using USDA-approved, eco-friendly products. We eliminate health threats while restoring clean, breathable air in your home.

Mold Testing & Lab Analysis
Identify exact mold types through our in-house lab. We provide targeted diagnostics that guide safe, effective treatment options for your property.

24/7 Emergency Water Mitigation
Burst pipe or flood? Our emergency team responds fast to stop water damage, prevent mold, and coordinate directly with your insurance provider.

Specialized Interior Remediation
From odor removal to post-construction cleanup, we sanitize interior spaces using safe, certified methods—ideal for families, pets, and sensitive environments.

Exterior Property Cleaning
Additional exterior cleaning services are available for roofs, decks, and siding to help prevent buildup and long-term damage.
Real Stories. Real Results.
What Homeowners Are Saying ABOUT US
See how our local team has restored comfort, safety, and health for homes across Hawley, Lake Ariel, and the surrounding counties.
FAQS
Frequently Asked Questions
Is your home mold removal process safe for children and pets?
Absolutely. We use USDA-approved, eco-friendly products specifically chosen to be safe for families—including children, pets, and houseplants.
How fast can you respond to a home water emergency in Hawley?
We offer 24/7 emergency water mitigation in Hawley and nearby towns. Our local crew responds quickly to protect your home’s interior, stop damage from spreading, and prevent mold growth when it matters most.
What is the average cost for home mold remediation?
Most residential mold remediation projects fall between $3,000 and $15,000, depending on the extent of contamination and affected interior areas—always with transparent pricing.
Can you test my home for mold even if I don’t see any visible growth?
Yes. We use advanced testing methods to identify hidden mold and indoor air quality issues, even when there are no visible signs in your home.
Do you work directly with home insurance companies?
Yes, we coordinate directly with your insurance to streamline the claims process and minimize stress during interior restoration and cleanup.
Can cleaning my roof and siding really prevent mold inside my home?
Yes. Regular exterior cleaning helps prevent leaks and moisture intrusion—two of the leading causes of mold growth inside walls, attics, and other interior spaces in Northeast Pennsylvania homes.